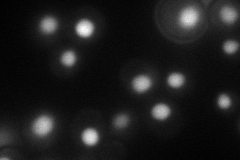
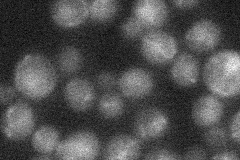

View description
Protein involved in regulation of nonhomologous end joining; interacts with DNA ligase IV components Dnl4p and Lif1p; repressed by MAT heterozygosity; regulates cellular distribution of Lif1p
Localization:
Intensity:
Fold change:
Significance:
-
C’ GFP library in SD

nucleus18.67 -
N' NOP1pr-GFP in SD
nucleus59.3275 -
N' TEF2pr-mCherry in SD

nucleus113.669 -
N' NATIVEpr-GFP in SD
ambiguous,nucleus17.271 -
N' TEF2pr-VC and Cyto-VN in SD

nucleus30.2649 -
C’ GFP library in SD+DTT

nucleus20.171.07No -
C’ GFP library in SD+H2O2

nucleus21.391.14No -
C’ GFP library in Starvation Media

nucleus19.151.02No -
C’ GFP library on the background of Pup2-DaMP

N/A -
C’ GFP library on the background of CCT mutant

N/A0N/AYes
